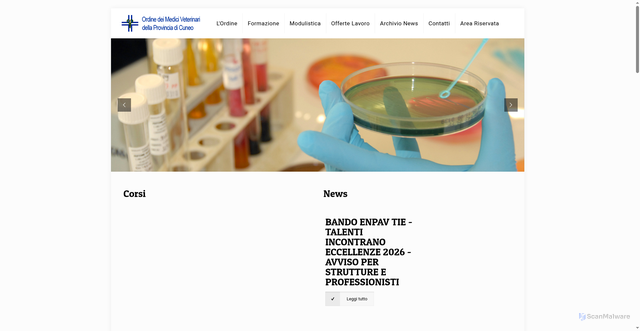
Security scan screenshot of https://www.veterinaricuneo.it/

Summary
This website contacted 1 IP in 1 country across 3 domains to perform 50 HTTP transactions. The main domain is veterinaricuneo.it and was registered NaN years ago.
Submitted URL: https://www.veterinaricuneo.it/
AI Security Verdict
Safe Website
Confidence: 96%
Legitimate professional site with no security concerns.
Safety Factors
Details
Page Title
Ordine Medici Veterinari Provincia di Cuneo
Scan Type
public
Language
Italian
Category
education learning
(54%)Domain Information
Domain 'www.veterinaricuneo.it' uses the Italian country-code top-level domain (.it), featuring subdomain 'www'. Count 15 characters in 'veterinaricuneo' split between eight vowels and seven consonants. Breaking it apart gives four words: ve, ter, inari, cuneo. Average segment length settles at 4 characters. No strong language cues emerged from the frequency lists.
Screenshot
Page Load Overview
Language Analysis
Primary Language
Detection Details
Website Classification
Primary Category
All Detected Categories
Detected Features
Domain & IP Information
| Requests | IP Address | Location | AS Autonomous System |
|---|---|---|---|
| 47 | 217.115.16.56 | Bruino, Piedmont, Italy | AS44084Multiwire S.r.l. |
| 47 | 1 | - | - |
Content Similarity HashesFor malware variant detection
TLSH (Trend Micro Locality Sensitive Hash)
Security-focusedSpecialized for malware detection and similarity analysis
ssdeep (Context Triggered Piecewise Hashing)
Context-awareDetects similar content even with modifications
sdhash (Similarity Digest Hashing)
High-precisionHigh-precision similarity detection for forensic analysis
These hashes enable detection of similar websites and malware variants by comparing content similarity even when exact matches aren't found.
Image Hashes
Perceptual Hashes
Other Hashes
Scan History
Scan history not available
Unable to load historical scan data